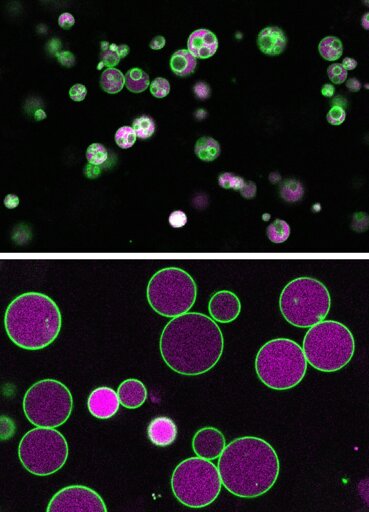

For most of their lives, plants get their energy from photosynthesis. But during the seed to seedling stage, when they can’t absorb light just yet, they rely on other sources, like fatty acids. To process the fatty acids, plant cells, like human cells, rely on a membrane-bound compartment called the peroxisome. For people interested in studying the peroxisome, plant cells are an excellent model to use.
From Biology News - Evolution, Cell theory, Gene theory, Microbiology, Biotechnology via This RSS Feed.
You must log in or # to comment.